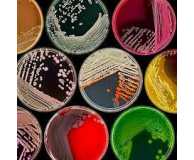
Microbiology

Consumables
- Discovering DNA
- Principles of Electrophoresis
- DNA Electrophoresis
- Investigating DNA
- Polymerase Chain Reaction (PCR)
- Discovering RNA
- Forensic Science
- Transformation & Genetic Engineering
- Medical Diagnostics
- Plant Biotechnology
- Protein & Enzyme Analysis
- Electrophoresis of Proteins
- Chromatography & Purification of Proteins
- Environmental Monitoring & Protection
- Microbiology

Postal Address
- PO Box 416
- Currumbin LPO
- Currumbin QLD 4223
Phone & Mobile
- (07) 5602 8002
- 0405 206 888
Fax
Email